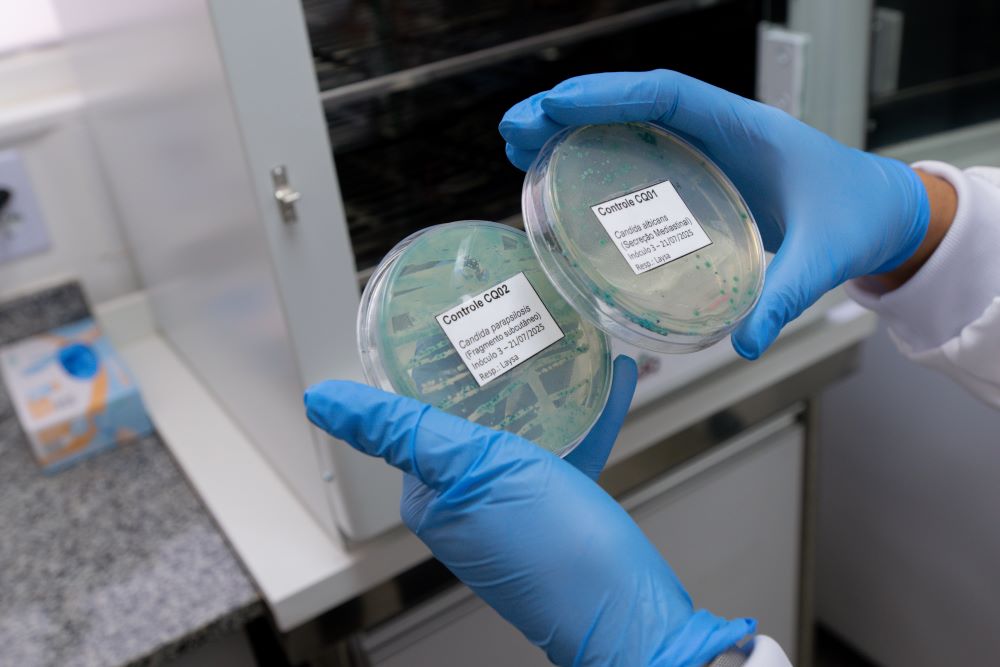
ㅤㅤ

Profissionais da UTI do HFA são capacitados para Vigilância Ativa de Fungos

Brasília-DF, 25 de agosto de 2025. A Divisão de Pesquisa da Direção Técnica de Ensino e Pesquisa (DTEP) do Hospital das Forças Armadas (HFA) realizou, nos dias 13 e 14 de agosto, um treinamento voltado à coleta de fungos na Unidade de Terapia Intensiva (UTI), como parte do projeto de pesquisa intitulado “Vigilância ativa de infecções fúngicas invasivas em pacientes idosos (60+) internados na UTI de um hospital militar do Brasil”. A capacitação envolveu profissionais de níveis técnico e superior da área de Enfermagem do hospital.

O Projeto, que integra atividades de parceria entre a UTI, Laboratório de Análises Clínicas (LAC) e Laboratório da Divisão de Pesquisa (Lab Pesq), teve como objetivo inicial preparar os profissionais de saúde para a coleta de amostras clínicas e ambientais, com foco no controle e identificação de fungos. A iniciativa conta com apoio financeiro da Fundação de Apoio à Pesquisa do Distrito Federal (FAPDF) e está vinculada ao Programa de Pós-Graduação da Universidade Católica de Brasília (UCB), sendo desenvolvida como parte da dissertação de mestrado de uma servidora civil enfermeira do HFA.

Os dados gerados visam subsidiar a implantação de um protocolo específico para a identificação de infecções fúngicas no ambiente hospitalar. Espera-se, com isso, aumentar a segurança do paciente e gerar indicadores a serem utilizados pela Serviço de Controle de Infecção Hospitalar e Vigilância Epidemiológica. As amostras, que serão processadas e analisadas pelo Laboratório de Pesquisa do HFA, serão coletadas a partir da participação voluntária de pacientes elegíveis (ou de seus responsáveis legais), mediante a assinatura do Termo de Consentimento Livre e Esclarecido (TCLE).
De acordo com a 2º Tenente Diane Oliveira, coordenadora do projeto e integrante da Divisão de Pesquisa, os resultados obtidos fornecerão dados laboratoriais e clínico-epidemiológicos relevantes para a saúde pública, em nível nacional e internacional. O monitoramento de espécies do gênero Candida, especialmente aquelas resistentes a antifúngicos, é uma recomendação da Agência Nacional de Vigilância Sanitária (ANVISA), do Ministério da Saúde (MS) e da Organização Mundial da Saúde (OMS), frente ao aumento de surtos e óbitos causados por leveduras pan-resistentes às terapias convencionais. “Esses dados terão impacto significativo e projetarão positivamente o HFA no cenário externo”, destacou.

O trabalho certamente trará mais qualidade e segurança ao paciente e proporcionará ao HFA ser referência no controle de infecções fúngicas no Distrito Federal e no Brasil. Um novo HFA!
HFA: UNINDO FORÇAS PELA SAÚDE
Assessoria de Comunicação Social do HFA